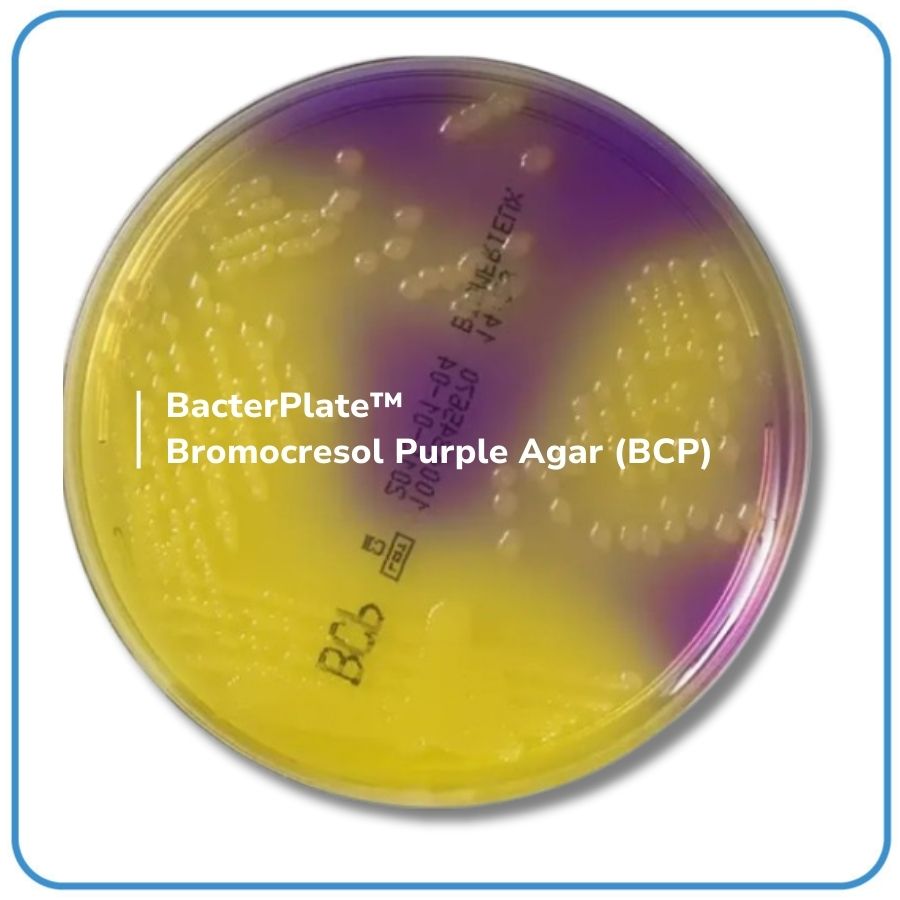

BacterPlate™ Bromocresol Purple Agar (BCP)
Mã: 05032
Mã đặt hàng/sản phẩm: 4102018
Số lượng tối thiểu: 1
Qui cách đóng gói:
10 đĩa/hộp
- BacterPlate™ Cetrimide Agar là một môi trường không chọn lọc, được sử dụng để phân biệt Enterobacteriaceae. Môi trường này được dùng để xác nhận sự hiện diện của coliforms trong khuôn khổ tiêu chuẩn T90 – 425, cho việc kiểm tra vi sinh vật của các thùng chứa và bao bì dùng trong đóng chai nước. Bao gói bằng màng bán thấm Cellophane film giúp cân bằng độ ẩm môi trường trong quá trình bảo quản.
- Thành phần trong 1L môi trường (tham khảo): Tryptone; Meat extract; Lactose; Bromocresol purple; Agar. pH của môi trường hoàn chỉnh ở 25°C: 7,0 ± 0,2.
- Quy cách: 10 đĩa/ hộp hoặc theo yêu cầu của khách hàng.
- Bảo quản lưu trữ: 2 – 8°C.
- Vận chuyển: Nhiệt độ môi trường.
- Hạn sử dụng: 04 tháng kể từ ngày sản xuất.
Danh sách đặt hàng

BacterPlate™ Bromocresol Purple Agar (BCP)
Mã: 4102018
Đơn vị: Đĩa
| Tên sản phẩm | Hình ảnh | Mã đặt hàng/sản phẩm | Đơn vị tính | Số lượng | Chọn vào giỏ hàng |
|---|---|---|---|---|---|
| BacterPlate™ Bromocresol Purple Agar (BCP) | | 4102018 | Đĩa |
